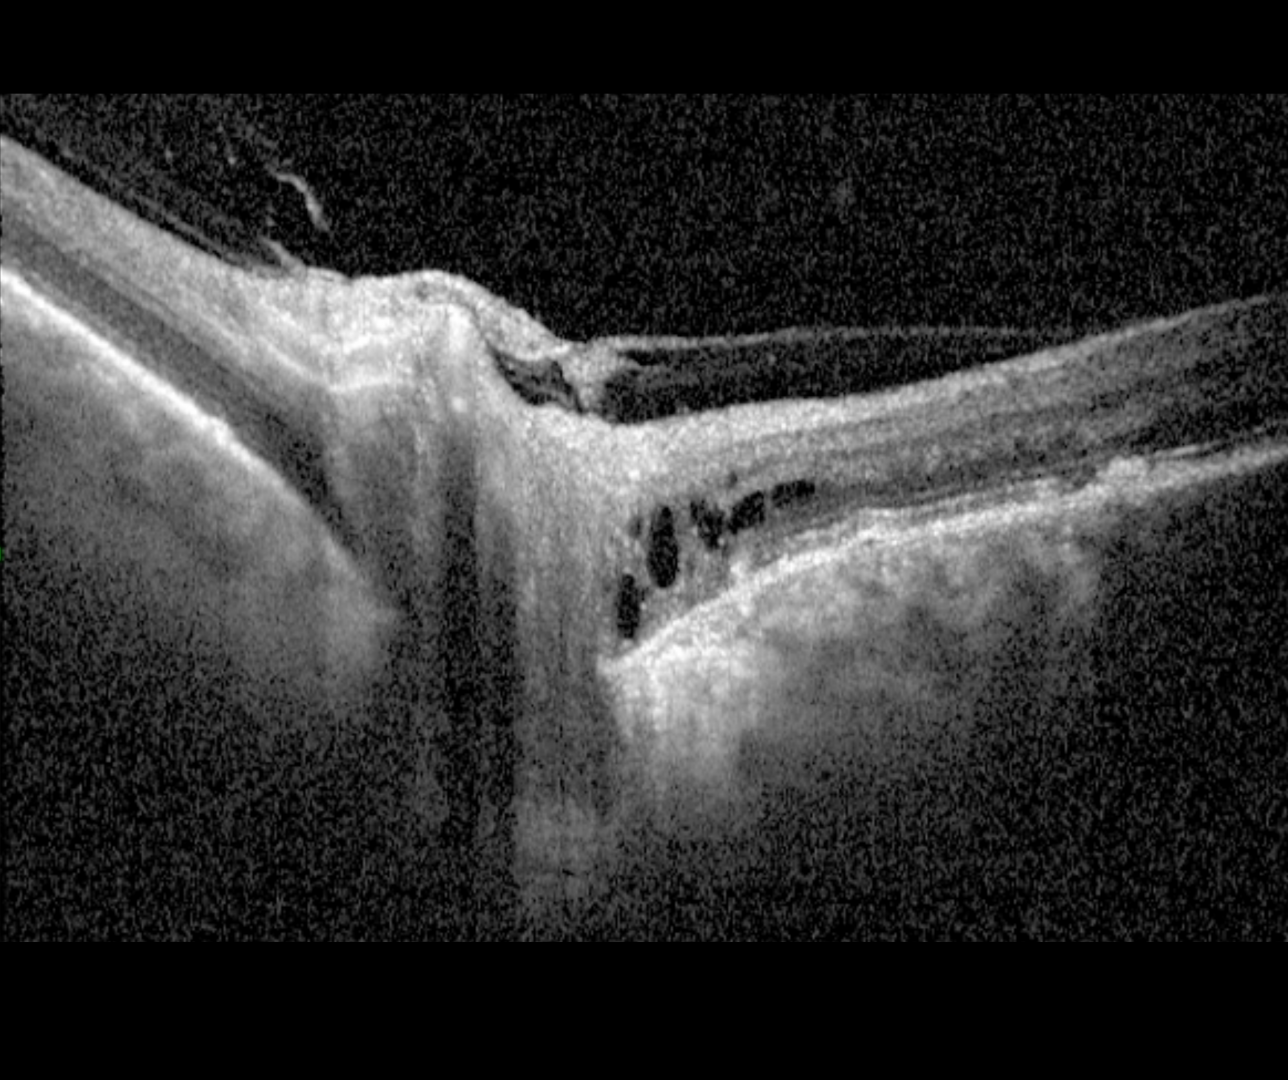

Overview
Peripapillary pachychoroid syndrome is an entity under the pachychoroid disease spectrum in which peripapillary choroidal thickening is associated with nasal macular intra and/or subretinal fluid. The optic disc typically has a crowded appearance or occasionally oedematous and RPE mottling and pachyvessels are seen on OCT using enhanced depth imaging.
Xu et al. (2020) found that approximately half of peripapillary pachychoroid syndrome cases have a peripapillary area of cystic fluid within the outer nuclear layer (ONL), located temporal to the disc and distinct from any other areas of intra-retinal fluid.
Case Examples
-
Case 1
A 77-year-old Middle Eastern female with best-corrected visual acuity of 6/9.5 (20/32) in the right and left eye.
Optomap (1), red separation (2) and green separation (3) images - right eye
More infoOptomap (1), red separation (2) and green separation (3) images - left eye
More infoFundus autofluorescence image (right eye)
More infoFundus autofluorescence image (left eye)
More infoSpectralis OCT line scans - superior right macula (1) and right optic disc (2)
More infoSpectralis OCT line scans (left optic disc)
More infoSpectralis OCT line scans (left macula)
More info -
Case 2
A 74 year old male, currently treated for hypertension. He reports an increase in stress recently, and also blur when trying to read in the morning (improving through the day). Visual acuity 6/7.5 OU.
Differential Diagnosis
References
Moraru, AD., Costin, D., Moraru, RL, Costuleanu, M, Brănișteanu, DC. (2020). Current diagnosis and management strategies in pachychoroid spectrum of diseases (Review). Experimental and therapeutic medicine, 20(4), 3528–3535.
Phasukkijwatana N, Freund KB, Dolz-Marco R, Al-Sheikh M, et al. (2018) PERIPAPILLARY PACHYCHOROID SYNDROME. Retina. 2018 Sep;38(9):1652-1667.
Xu D, Garg E, Lee K, et al. Long-term visual and anatomic outcomes of patients with peripapillary pachychoroid syndrome. British Journal of Ophthalmology Published Online First: 21 December 2020.


